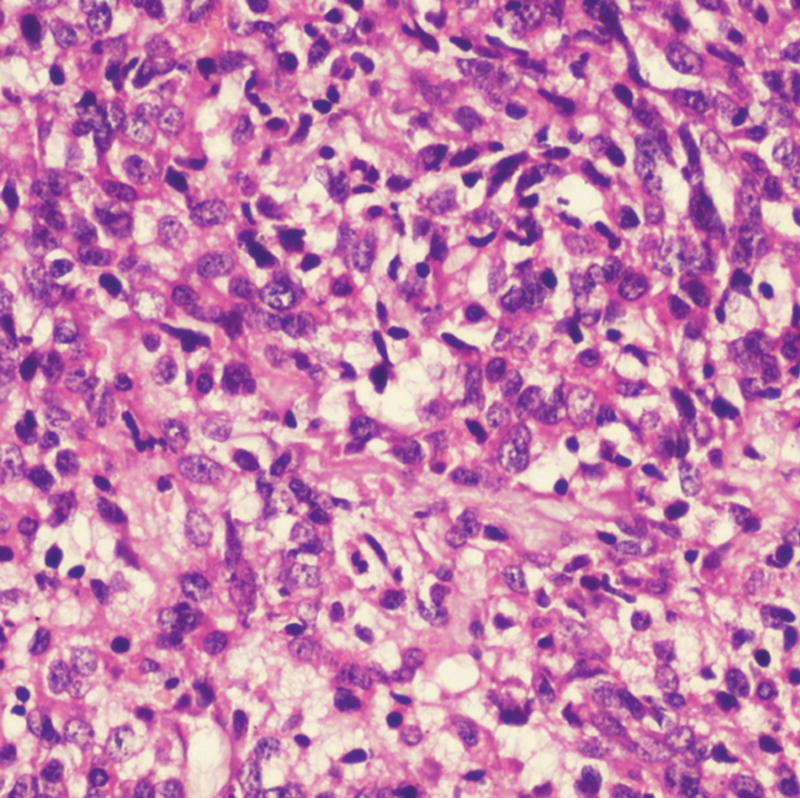

Hematoxilina modificada según Mayer para la tinción nuclear
Reactivo utilizado para la tinción progresiva en histopatología y la contratinción en inmunohistoquímica.
A diferencia de otras formulaciones de hematoxilina, la hematoxilina modificada según Mayer no contiene alcohol, lo que la hace adecuada para su uso en reacciones con aminoetilcarbazol cromogénico (AEC), que son solubles en alcohol.
500 ml